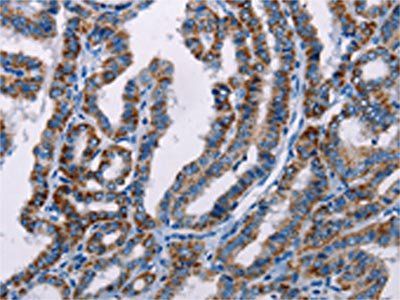
FHIT Antibody

You have no items in your shopping cart.
Human FHIT Protein
SKU: orb425524
Description
Images & Validation
−
| Application Notes |
|---|
Key Properties
−| Source | Escherichia Coli |
|---|---|
| Protein Sequence | MSFRFGQHLI KPSVVFLKTE LSFALVNRKP VVPGHVLVCP LRPVERFHDL RPDEVADLFQ TTQRVGTVVE KHFHGTSLTF SMQDGPEAGQ TVKHVHVHVL PRKAGDFHRN DSIYEELQKH DKEDFPASWR SEEEMAAEAA ALRVYFQLEH HHHHH |
| Purity | Greater than 95% as determined by SDS-PAGE. |
Storage & Handling
−| Storage | Stability: Store at 4°C if entire vial will be used within 2-4 weeks. Store, frozen at -20°C for longer periods of time. For long term storage it is recommended to add a carrier protein (0.1% HSA or BSA).Avoid multiple freeze-thaw cycles |
|---|---|
| Form/Appearance | Sterile filtered colorless solution. |
| Buffer/Preservatives | FHIT Human solution containing 20mM Tris-HCl pH-8 & 10% glycerol. |
| Expiration Date | 6 months from date of receipt. |
| Disclaimer | For research use only |
Alternative Names
−EC 3.6.1.29, Dinucleosidetriphosphatase, Bis (5''-adenosyl)-triphosphatase , AP3Aase, AP3A hydrolase, Diadenosine 5'',5''''''-P1,P3-triphosphate hydrolase, FRA3B.
Similar Products
−
Quality Guarantee
Explore bioreagents carefree to elevate your research. All our products are rigorously tested for performance. If a product does not perform as described on its datasheet, our scientific support team will provide expert troubleshooting, a prompt replacement, or a refund. For full details, please see our Terms & Conditions and Buying Guide. Contact us at [email protected].
Documents Download
Datasheet
Product Information
Request a Document
Protocol Information
Human FHIT Protein (orb425524)
Based on 0 reviews
Participating in our Biorbyt product reviews program enables you to support fellow scientists by sharing your firsthand experience with our products.
Login to Submit a Review